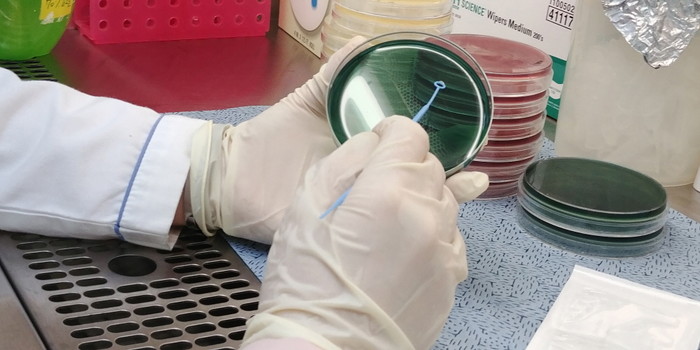

|
1일 도에 따르면 4월부터 비브리오패혈증균 감시사업을 실시해 한 달여 동안 해수 14건, 갯벌 11건, 어패류 15건을 검사했으며 이 가운데 지난달 24일 채수한 해수에서 균을 분리했다고 밝혔다.
이는 지난해보다 1주일가량 늦은 것으로 지난해는 4월 17일 채수한 바닷물에서 비브리오패혈증균이 검출됐었다.
비브리오패혈증은 전국적으로 연평균 50명 안팎의 환자에서 발생해 절반 가까이 사망(치사율 50%)하는 제3군 법정감염병이다. 주로 온도가 상승하는 5~10월 사이에 많이 발생하며, 비브리오 패혈증균에 오염된 어패류를 생식하거나 오염된 바닷물이 상처와 접촉할 때 감염될 수 있다.
|
| ▲바닷물에서 분리한 비브리오패혈증균.(경기도 제공) |
경기도에서는 2013년과 2014년에는 8월, 2015년에는 6월, 2016년 2월, 2017년 4월에 첫 비브리오패혈증 환자가 발생하는 등 출현시기가 조금씩 빨라지고 있다.
경기도의 연간 비브리오패혈증 환자발생은 2013년 9건, 2014년 8건, 2015년 6건에서 발생시기가 상대적으로 빨랐던 2016년 12건, 2017년에는 10건으로 증가세에 있어 주의가 필요하다.
윤미혜 경기도보건환경연구원장은 “비브리오패혈증은 감염병 중에서도 치사율이 매우 높기 때문에 감염예방과 신속한 대처가 중요하다”면서 “어패류는 85℃ 이상으로 익혀먹고 피부 상처가 있을 경우 바닷물과의 접촉을 피하는 것이 좋다”고 말했다.
[저작권자ⓒ 로컬(LOCAL)세계. 무단전재-재배포 금지]





























